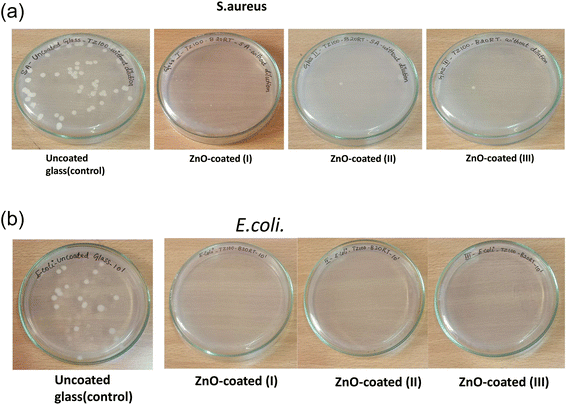
image file: d5fb00593k-f6.tif

Investigation of the antibacterial activity of sputtered ZnO coating on borosilicate glass: a nanostructured approach for food packaging
Received
12th September 2025
, Accepted 24th November 2025
First published on 25th November 2025
Abstract
In this study, nanostructured ZnO is sputter-coated on a 7059 corning borosilicate glass substrate via RF magnetron sputtering to explore its potential application in antimicrobial food packaging. Surface characterization via FE-SEM and XRD, contact angle measurement, transmittance measurement via UV visible spectroscopy, and antibacterial testing against E. coli and S. aureus have been conducted to evaluate the coating. Antimicrobial studies have shown excellent activity against E. coli (100%) and S. aureus (83.25%). The coating's stability was evaluated over 120 hours. The findings highlight the potential of sputtered ZnO coatings as active antimicrobial barriers for glass-based food packaging as well as healthcare packaging, offering enhanced hygiene, safety, and shelf-life extension for perishable products.
1 Introduction
Maintaining food safety and prolonging shelf life are critical concerns for consumers and industries in today's fast-paced life. Foodborne illness is a worldwide public health concern. Foodborne contamination causes millions of illnesses, thousands of hospitalizations, and even fatalities worldwide.1 The 1st edition of World Health Organization (WHO) in collaboration with WHO Foodborne Disease Burden Epidemiology Reference Group (FERG) estimated illness of 600 million people due to hazardous contaminants including bacteria, viruses, parasites, chemicals, and toxins by the year 2050. The reports estimate the mortality of 420
000 people due to unsafe food, out of which 125
000 deaths estimated were of children below age 5.2 The estimated risk factor in 2025 would increase by 10 million due to drug-resistant microbes.3 There is an urgent requirement to adopt a cutting-edge method to manage and control foodborne infections. Packaging has a key role in ensuring the quality, freshness, and safety of food products during storage and transportation. Active packaging materials, which help in prolonging the shelf life of perishable foodstuffs while maintaining the freshness and quality are of prime importance.4 With the rising urbanization and industrialization, the requirement of packed food has pushed packaging materials and their quality to the research domain.5 In the same line, freshness indicators and sensors actively monitor spoilage and help reduce waste.6 Zhang et al. effectively combined antimicrobial agents with monitoring mechanisms to effectively maintain meat quality and safety.7
Though polymer and composite-based packaging are popular in healthcare as well as food industries, glass packaging still stands out due to its chemical inertness, barrier properties, and recyclability.8 Plastic food packaging is highly discouraged now, owing to its sensitivity to environmental factors like oxygen, vapours, and light, resulting in facultative bacterial and/or fungal growth. In addition, the fear of microplastic leaching and carcinogens after heating/cooling the food still exists with this packaging.9 Recycling of plastic-based packaging has also become one of the major concerns in the food packaging industry. Aluminium on the other hand has gained popularity in food packaging industries since the early 20th century due to its low density and malleability.10 Aluminium has been used in various forms, such as foil, tubes, bottles, laminated and metallized films,11 tetra packs, metal containers, and lids. However, both glass and metal (Al) containers are susceptible to microbial contamination on their surfaces, which may compromise food safety and shelf life.12,13 At the same time, leaching of Al in food has been suspected to be correlated with patients having Parkinson's and Alzheimer's diseases.14 Wastage of foods due to poor packaging has now become a major concern on long haul flights for airlines as studied by M. Halizahari et al., indicating the need to enhance the shelf-life of food via better packaging options.15
The growing desire for higher food safety, shelf-life extension, and sustainability has become a pivotal priority in the global food packaging industry, leading to smart packaging or “active packaging”. Modern packaging would not only protect stored stuff from contamination but increasingly function as a barrier against environmental contaminants and microbial invasion. The emergence of smart coatings, particularly those with antimicrobial properties, has opened new pathways in food preservation technology. For example, bionic pearl layer and bionic cicada wing are getting attention due to enhanced mechanical barrier properties and physical bactericidal activity.16 Despite huge progress in biomimetic materials, formidable challenges, like the reaction between these materials and the organic acids in food, expansion of these materials due to moisture adsorption from food, and food components' (salt, polysaccharides, oil) reactions with the biomimetic material, still exist.17 Zein self-assembled nanoparticles (NPs) can also be used in food preservatives to protect the shelf-life of food. The zein NPs may be controlled through temperature, polarity of the solution, pH, strength of ions and proportion of polymers.17 Zein NPs and ε-polylysine help to fight fungal infection to extend avocado's shelf life.17,18 Also, zein, lecithin, and epigallocatechin gallate keep loquat fresh.17 Zein NP coating can also be used to preserve meat.17,19 Nevertheless, zein NPs with controlled shapes and sizes need to be designed to enhance the stability and loading capacity in practical applications. Wang et al.20 proposed a self-healing material (viz., polyelectrolyte multilayer film (PEM)) for food packaging. PEM consists of sodium carboxymethylcellulose and chitosan. PEM film is a good anti-oxidant, exhibiting antibacterial properties along with self-healing capabilities. But these films need to be activated by water for their self-healing capabilities. Recently, essential oil-based systems, such as citral–eugenol microcapsules, have shown synergistic antifungal activities against Aspergillus niger, enhancing film hydrophobicity and increasing the shelf life of bread from 4 to 10 days.21
Furthermore, zinc oxide (ZnO) has gained significant attention in active packaging due to its multifunctional capabilities in food-grade coatings.22–24 It has lower cytotoxicity, more biocompatibility, and better stability, and is chemically inert and transparent, with UV-blocking capability, and most importantly, it shows antibacterial25 and antifungal activities.26 All these properties make ZnO coatings particularly suitable for food packaging applications, where microbial control is crucial. The use of zinc oxide nanoparticles as a biomarker, biosensor27,28 and drug delivery agent29–31 is also extensively explored. The antibacterial action of ZnO is attributed to mechanisms such as reactive oxygen species (ROS) generation, Zn2+ ion release, and direct interactions with microbial cell walls, leading to membrane disruption and eventual cell death.25 These effects have been widely demonstrated against a broad spectrum of foodborne pathogens including Staphylococcus aureus (S. aureus), Escherichia coli (E. coli) and Aspergillus niger (A. niger).32,33 ZnO coatings have shown encouraging antibacterial activity when applied to glass substrates without affecting the optical or structural characteristics of glass.34
While ZnO incorporation into borosilicate glass enhances functional properties such as bioactivity, antibacterial efficacy, or luminescence, it concurrently compromises optical transparency. Fathy Abdel-Wahab et al.35 doped borosilicate glass with chromium and co-doped it with ZnO. The authors reported a clear reduction in visible light transmittance as ZnO concentration increases, which disrupts the glass network and promotes absorption and scattering. Similarly, Mohd Hafiz Mohd Zaid et al.36 explored the effect of ZnO doping in soda-lime silicate glasses and observed that ZnO incorporation shows band-gap narrowing37 and elevated visible absorption, suggesting comparable spectral effects in soda lime glass systems. Furthermore, terbium-activated zinc borosilicate matrices form ZnO and willemite crystalline phases upon heat treatment, indicating that phase separation compromises clarity even as luminescence intensifies, as represented by Sena Dayioglugil et al.37
Collectively, these studies confirm that ZnO incorporation at varying concentrations tends to reduce the optical clarity of borosilicate glass, posing a trade-off between functionality and transparency of such glass-based packaging. In addition to antibacterial activity, ZnO-infused barrier coatings improve the packaging film's resistance to moisture, oxygen, and grease, all of which are essential for maximising shelf life. Nanostructured ZnO thin films have variable thickness and morphology that directly affect their antibacterial activity, particularly when deposited using methods like DC reactive sputtering or RF magnetron sputtering.38,39 The ZnO nano particles (NPs) can be synthesized using various green synthesis methods and are coated onto the packaging surface.40 Fabricating thin ZnO films via techniques such as RF magnetron sputtering in food packaging offers several advantages, including uniform coating, high adhesion, and room-temperature processing. These coatings can be deposited on various packaging substrates like borosilicate and soda-lime glass to enhance not only their antimicrobial performance but also to preserve the sensory and nutritional qualities of the food contents by inhibiting microbial growth. Despite the growing interest in ZnO coatings for biomedical41 and optoelectronic applications,42,43 their potential in food packaging remains limited as a coating on glass for packaging and is yet to be explored. Although direct coating on glass substrates is limited in this area, a few studies such as functionalization of silver (Ag) for Al-doped ZnO coatings on polylactic acid (PLA) substrates,44 ZnO/graphene oxide/montmorillonite antibacterial coating on (polyethylene) PE substrates,35 and coatings for food contact surfaces13,45 highlight the wide potential and need for further research.
The current study investigates the structural, morphological, optical, and antibacterial properties of RF magnetron sputtered ZnO coating on borosilicate glass substrates. By analysing the influence of coating texture, transparency, stability, and its antibacterial activity against clinically relevant bacteria, this work aims to contribute to the development of safer, longer-lasting, and more sustainable food packaging systems.
2 Experimental details
2.1 Fabrication of ZnO thin film coating on 7059 glass substrates via sputtering
The glass substrate was cleaned using the standard substrate cleaning method.46 The substrate was first cleaned using lobeline solution and then sonicated using DI water and then acetone for 10 minutes. The cleaned substrates were then dried in a nitrogen environment, ensuring an ultra-clean substrate surface. A thin coating of ZnO was deposited using RF magnetron sputtering (HHV-high vacuum model) at room temperature. Fig. 1 represents the schematic diagram of RF magnetron sputtering. It is a thin-film deposition technique that uses radio frequency power. It is widely used for depositing insulating or composite materials with excellent adhesion, density, and compositional control. ZnO (∼99.99%) purity target of diameter 75 mm was used as a cathode to sputter deposit the coating. The distance between the target and substrate was kept at ∼10 cm. Substrates (glass 7059) were placed on the anode with the help of copper tapes. The base pressure in the vacuum chamber of ∼10−6 mbar was achieved using a turbo molecular and rotary pump combination. The argon gas was purged inside the chamber, and a constant argon pressure of 4 × 10−2 mbar was maintained in the chamber. The RF power of 100 W was applied between the cathode and anode for 120 minutes. Argon gas was used as a sputter gas for generating the plasma. High-energy Ar ions in the plasma bombarded the ZnO target, and ZnO was deposited on the substrate by momentum transfer. The colour of the plasma depends on incident ions and the cathode material. In this case, the colour was pink. In this study, a ZnO coating was developed on 7059 corning borosilicate glass substrates. Two types of coatings were fabricated: (a) one side coated with a step (created using Teflon tape), (b) both sides coated.
 |
| | Fig. 1 Schematic representation of RF magnetron sputtering. | |
2.2 Characterization and testing
The thickness of the coating was determined using a depth profilometer (Bruker DektakXT). The adhesion of the film with the substrate was tested by the peel test method using Kapton tape. The tape was placed on the coated substrate and manually peeled off at an angle of 90°. The crystallographic structure of the film was determined with an X-ray diffractometer (Empyrean PANalytics diffractometer). The optical properties were determined with the help of a UV-visible spectrometer (PerkinElmer LAMBDA 365), and the transmittance spectra were taken between 350 and 800 nm. The structural morphology and particle size were studied using field effect scanning electron microscopy (FE-SEM, Hitachi S-4800) and analysed through ImageJ software. The contact angle of the coatings was determined through a goniometer contact angle measurement instrument (ramè-hart Instrument Co.). The antibacterial activity of the coated thin films was determined against Staphylococcus aureus (S. aureus) and Escherichia coli (E. coli), using quantitative microbiological techniques.
3 Results and discussion
3.1 X-ray diffraction: crystallographic analysis
The structural morphology of the ZnO thin films was determined via the glancing angle X-ray diffraction method. Copper Kα1 radiation with 0.154 nm was used over a scan range of (2θ) 20° to 80° with a scan rate of 0.02° s−1. A hexagonal phase with a wurtzite structure (JCPDS file no. 36-1451) has been identified47 in the deposited zinc oxide thin film (Fig. 2). The ZnO film is textured along the (002) plane with low-intensity peaks at (102), (103), and (112) as shown in Fig. 2. The preferential orientation of the films was observed to be the (002) plane; the texture coefficient (TC) was determined using eqn (i)48 and is represented in Fig. 2 (inset).| |
 | (i) |
where Is(hkl), is the standard XRD intensity of the corresponding (hkl) peak, Io(hkl) is the observed intensity, and n is the total number of peaks observed. The grain distribution of the coated films is determined from the texture coefficient; if TC(hkl) < 1, then grain development is random; if TC(hkl) > 1, then grain growth in the (hkl) plane is preferential. The obtained TC(002) is 3.868 which is the highest among the observed peaks, hence it can be concluded that the (002) plane is the most preferred orientation of the crystal growth. The preferential texturing is related to the minimized internal stress and surface energy in the films as discussed by authors Norifumi Fujimura et al.,49 and Dinghua Bao et al.50 Enmao Xiang et al. reported a significant contribution of surface roughness to antibacterial properties in Zn metal films,51 indicating the importance of surface in antibacterial properties. The average crystallite size of the particles was determined using the Scherrer equation| |
 | (ii) |
where β is the full width at half maxima value of the diffraction peak (in radian), K is the numerical factor (constant = 0.9) which depends on the shape of the crystallite, λ is the wavelength of the X-ray source, and θ is the diffraction angle.52–54 The average crystallite size of ZnO obtained by using eqn (ii) is approximately 18 nm for ZnO coating on 7059 corning glass substrates.
 |
| | Fig. 2 X-ray diffraction pattern of sputtered coated ZnO thin films, the film is textured along the (002) plane with the ZnO hexagonal phase identified using JCPDS card no. 36-1451. The inset table represents the texture coefficient value of identified planes. | |
3.2 Structural morphology and elemental analysis
3.2.1 Thickness and adhesion test. The thickness of the deposited thin films was determined using a depth profilometer (Bruker DektakXT model). The measured thickness of the coatings is ∼50 nm. P. Carvalhoa et al.55 employed the cross-sectional SEM analysis method to estimate the thickness of the DC sputtered coating of pure ZnO and Ag-doped ZnO on a silicon substrate. The authors observed that the coating thickness varies between 50 and 100 nm during a 2-hour deposition time and has a similar granular morphology to that reported in this work in the Scanning electron microscopy section.The adhesion of the coating with the substrate was tested using Kapton tape, the tape was placed on the coating and peeled off, as represented in Fig. 3 (both 48 Mega Pixel camera and optical images (20× magnification) were taken for better representation). The coating remained intact on the substrate, thus showing strong adhesion of the ZnO coating on the glass substrate. In further sections, the stability of these coatings in an aquatic environment over a long period is also studied.
 |
| | Fig. 3 Visual inspection images of ZnO coatings taken using a camera (48 Mega Pixel) and optical images (20× magnification) before and after the peel-off test, showing no change indicating the highly adhesive ZnO coating deposited on the glass substrate. | |
3.2.2 Optical properties. The optical properties were determined from the transmittance measurement of the synthesized zinc oxide coatings for both side coated substrates in the range of 280–800 nm via a UV-visible spectrometer (PerkinElmer LAMBDA 365), as shown in Fig. 4 and the inset.
 |
| | Fig. 4 UV-visible transmittance spectra of both side ZnO coated 7059 glass substrates; the inset shows the images of the transparent coatings. | |
The UV-visible transmittance spectrum (Fig. 4) of the ZnO coating reveals a sharp edge around 375–400 nm and transmittance above 80%. This indicates strong absorption in the UV region, effectively blocking harmful ultraviolet radiation through the sputtered film. The transmittance increases steeply to 85% and then gradually approaches nearly 100% around 700 nm in the visible range. This high optical transparency confirms the suitability of the ZnO coating for applications in UV-shielding films as well. A. Ismail et al.56 studied the optical properties of ZnO coating, which was RF sputtered at different powers (150–250 W) and obtained an optical transmittance of 70–80%. Alireza Samavati et al.57 also studied the effect of thickness on the optical properties of RF-deposited ZnO films and got similar results. The minimal absorption and scattering in this region also suggest good film uniformity and surface smoothness. These findings are consistent with previous reports57 that highlight the excellent optical properties of ZnO thin films, including their wide bandgap and high transmittance in the visible spectrum.
3.2.3 Scanning electron microscopy. The structural morphology of the coated film on the 7059-borosilicate substrate was observed using field emission scanning electron microscopy (FE-SEM). The sputtered ZnO coating exhibits compact grain morphologies (Fig. 5a), indicating the formation of densely packed nano crystallites. The EDX spectrum (Fig. 5b) confirms the presence of Zn and O as the primary constituents of the coated films, with no significant impurities detected. The particle size distribution was determined via FE-SEM analysis (ImageJ software);58 the particle size distribution analysis (Fig. 5c) revealed an average particle diameter of 21.52 ± 1.27 nm. The Gaussian fit curve indicates a narrow size distribution, suggesting controlled growth conditions during the deposition, resulting in uniform particle size. The borosilicate substrate acts as a nucleation site at room temperature and 100 W applied RF power. P. Carvalho55 observed similar granular morphologies of ZnO NPs grown at room temperature via DC reactive magnetron sputtering. This nanoscale grain structure was reported to be favourable for improving surface-dependent functionalities, such as antimicrobial and wettability behaviour.40,59,60
 |
| | Fig. 5 FE-SEM images of ZnO coated film at 100 nm scale (a–c): (a) FE-SEM image of coated 7059 substrates at 50 000× magnification; (b) EDX spectrum confirms the presence of Zn and O; (c) particle size distribution as observed via FE-SEM analysis. | |
3.3 Antibacterial testing
The coated ZnO thin films were tested for the desired potential use as an antibacterial coating. The antimicrobial efficacy of ZnO coating was tested against two microorganisms, Gram-positive Staphylococcus aureus and Gram-negative Escherichia coli bacterial strains for a 24-hour incubation period. The nutrient broth and Muller Hinton Agar were procured from Hi-media. To prepare the bacterial cultures, 0.13 g of nutrient broth powder was dissolved in 10 mL of distilled water and sterilized. The bacterial inoculum was introduced into the broth and incubated at 36 ± 1 °C for 24 hours under aerobic conditions to ensure active bacterial growth.
Following incubation, 1 mL of the bacterial culture was diluted in 9 mL of sterile distilled water to achieve a 105-fold dilution. Then, 100 µL of this diluted bacterial suspension was pipetted onto the surface of the test films. The samples were incubated in a humidified chamber at 37 °C for 24 hours to facilitate bacterial adhesion and interaction with the coated surface. Post-incubation, the bacterial inoculum was recovered by gently resuspending the remaining liquid on the film surface. The recovered suspension underwent a series of tenfold serial dilutions (10−1 to 10−4). From each dilution, 50 µL was plated onto Mueller Hinton Agar plates, which were subsequently incubated at 37 °C for 24 hours. The experiment was performed in triplets represented here as ZnO coated (I), (II), (III) for each bacterium, as shown in Fig. 6a and b.
|
| | Fig. 6 The antibacterial activity on the agar plate after an incubation period of 24 hours, for (a) S. aureus and (b) E. coli for ZnO-coated glass thin films. The uncoated glass substrate is the control. | |
Colony-forming units (CFUs) were calculated from the agar plates corresponding to each dilution. The CFU concentration in the recovered suspension was calculated using the following formula:
Fig. 7(a) represents the percentage killing in the coated film in comparison to the control (uncoated 7059 glass) substrate. The results revealed a highly potent bactericidal effect against E. coli, with 100% killing, followed by 83.25% against S. aureus. The particle size and morphology play an important role in enhancing the antibacterial activity of ZnO nanomaterials against Gram-negative and Gram-positive bacteria.61 Surface morphology is known to vary with deposition parameters for ZnO NPs.62 The deposited ZnO nanoparticles grown by RF magnetron sputtering at room temperature have shown the island growth of spheroid-like morphologies (Fig. 5a). The grown ZnO nanoparticles have a high specific surface area, due to a smaller particle size of 18–21 nm, as confirmed on the basis of XRD and FE-SEM results, with a slightly hydrophobic surface having a contact angle of 93.7° as shown in Fig. 7b. As the observed hydrophobicity of the coating is very small according to the contact angle, there is high probability of bacterial colonies on the coating. The enhanced S. aureus and E. coli killing with respect to control indicates an active killing.
 |
| | Fig. 7 (a) Antibacterial activity of the coated sample compared to the uncoated sample. (b) Contact angle image of ZnO coating on the 7059 substrate. | |
The NPs in the coating have a smaller particle size which may easily rupture the cell wall of Gram-negative bacteria with the thickness of the cell wall varying between 7 and 8 nm, as demonstrated by Rafel Alvarez Chimal et al. in their study. The authors have demonstrated the influence of particle size on the antibacterial activity of green-synthesized ZnO and also confirmed the interaction between ZnO NPs and bacterial protein through molecular docking analysis.60 The fabricated ZnO film having a smaller particle size may be able to rupture the cell wall of bacteria, resulting in reduced bacterial activity. The molecular docking analysis experiment may be undertaken in the future to confirm the bacterial killing mechanism for the RF sputtered ZnO coated glass. Krishna R Raghupathi et al.63 studied the size dependent bacterial inhibition of ZnO NPs and their mechanism against S. aureus, and concluded that the killing was inversely proportional to the size of NPs. Nataliya Babayevska et al.64 have also shown similar results for lower particle size nanoparticles and nanorods of ZnO, having comparable killing of bacteria against uncoated samples for both S. aureus and E. coli. The killing or inhibition of bacteria in the literature has been summarized and represented in Table 1.
Table 1 Comparison of bacterial killing in active packaging
| Bacteria |
Material and technique |
% Killing |
Particle size |
References |
| E. coli |
ZnO doped soda lime glass |
99.82% |
— |
8 |
| E. coli |
Ag2O doped soda lime glass |
99.99% |
— |
65 |
| E. coli |
5% ZnO doped borosilicate glass |
99.29% |
— |
66 |
| E. coli |
Sputter coated ZnO |
100% |
18–21 nm |
This paper |
| S. aureus |
Green-synthesized ZnO |
Higher zone of inhibition |
(∼12 nm) |
63 |
| S. aureus |
Green-synthesized ZnO |
Higher zone of inhibition |
(∼4–10 nm) |
60 |
| S. aureus |
Sputter coated ZnO |
83.25% |
18–21 nm |
This paper |
A scalable and affordable option for glass container applications in the food and pharmaceutical industries is soda-lime glass doped with 5% ZnO, which demonstrated 99.82% inactivation of E. coli.8 The same group doped 2% Ag2O and showed 99.99% killing of E. coli in antibacterial soda lime glass in comparison with undoped glass.65 Furthermore, they reported that 5% ZnO incorporation in borosilicate glass for pharmaceutical packaging leads to the antibacterial inactivation of 99.29% E. coli.66 The study further concludes that the leaching of ZnO may occur, which is below the toxicity level. In comparison to the literature, E. coli and S. aureus killing is greater in our results (see Table 1). The smaller particle size of ZnO crystallite in the deposited coating along with the strong texturing along (002) have probably contributed to 100% and 83.25% killing of E. coli and S. aureus, respectively.
3.4 Stability evaluation of ZnO coating under simulated moisture conditions
Hajer Rokbani et al.67 evaluated the long- and short-term antibacterial properties of low-density PE (polyethylene) films coated with ZnO NPs, for food packaging. ZnO-coated LDPE-g-AM (Bynel) films exhibited strong and long-lasting antibacterial activity, especially against E. coli, due to uniform nanoparticle distribution and strong surface adhesion. These films on PE remained effective even after eight months and ultrasonic washing, unlike standard LDPE films. This highlights their potential as durable, passive antibacterial coatings for food packaging applications.
To evaluate the long-term stability of the ZnO coated films under simulated aqueous environment conditions for food packaging, both side coated substrates without a stepped edge were completely immersed in 20 ml of deionized (DI) water in a glass beaker and kept in an isolated environment for over 120 hours. Before the stability test, the coating was kept under ambient conditions for 5 months after deposition. The coatings were evaluated across the edge and in the middle region of the surface to distinguish any variation, allowing visual tracking of the degradation (Fig. 8a–d). Microscopic images of the coating were taken to understand the variation in thickness/surface morphology at defined time intervals (0, 24, 72 and 120 hours) at 20× magnification.
 |
| | Fig. 8 Optical images of ZnO coatings after immersion in DI water (a) 20× magnification coating before immersion, (b) after 24 hours of immersion, (c) after 72 hours of immersion (d) after 120 hours of immersion. The inset images represent the edges of the coating. | |
In the initial hour (zeroth hour, Fig. 8a), the coated surface appeared uniform with a clearly defined interface and no evidence of defects, pits or delamination. The coating adhered well to the substrate, indicating satisfactory film integrity even after being exposed to an ambient environment for more than 5 months of deposition. Upon 24 hours of immersion in DI water (extreme exposure to moisture and oxidising conditions) (Fig. 7b), a subtle variation can be observed near the edge, potentially due to the initial hydration effect. Since the coating used exhibits a water contact angle of 93.7°, with a slightly hydrophobic surface, it gives a barrier, though weak, to water retention in the initial hours, without substantial mechanical failure. The continuous exposure to moisture did not show much surface transformation in 72 hours (Fig. 8c). After 120 hours (Fig. 8d), the subtle beginning of delamination was observed at the coating edge, whereas the middle region is observed to be stable. Álvaro Garrido-López et al.,11 studied the delamination mechanisms of multilayer packaging of aluminium foil and polyethylene (PE) via XPS, FTIR and Tof SIMS analysis. Their results indicated that chemical delamination was mostly caused by the reaction of migrated molecules with adhesive-aluminium bonds, whereas the breaking of van der Waals bonds leads to delamination of extruded materials. The authors reported similar degradation pathways in oxide and polymer hybrid coatings, where water uptake leads to hydrolytic cleavage or loss of adhesion. Similarly, Ghislain Fotie et al.68 evaluated the effect of moisture on cellulose nanocrystals (CNCs) used in food packaging for high gas barrier protection. They coated a PET substrate with CNCs, and the solubility results indicated that the integration of hydrophobic coatings would lead to the reduction of the delamination process.
This study highlights the coatings' stability for food packaging used for a shorter duration. Additionally, the promising adhesion even after 5 months in the ambient environment strongly suggests the possibility of this coated glass in packaging to store dry food products. Enhancing the moisture resistance of the coating through improved cross-linking, hydrophobic modification, or incorporation of barrier layers would further improve the coating stability over a longer duration. Moreover, the time-based imaging approach provides a simple yet effective technique for evaluating coating reliability in the presence of environmental stimulants. These antibacterial, transmittance and stability results are highly encouraging to consider the ZnO sputter coating on borosilicate as sustainable, multifunctional materials for active food packaging applications. This work shall be extended in future to other wrapping films used for packaging.
4 Conclusion
ZnO nanofilms were successfully coated on 7059 corning glass via RF sputtered deposition. The deposited film is highly dense, exhibits homogeneous granular morphology and textured (TC = 3.87) along the 002 plane having a crystallite size of 18 nm. FE-SEM revealed a grain size of ∼21 nm diameter. Antimicrobial studies showed excellent activity against E. coli (100%) and S. aureus (83.25%). The preferential film orientation and smaller particle size could be the reason for the observed improved antibacterial activity of the ZnO material. The stability study indicated strong adhesion even after exposure to the ambient environment for approximately 5 months, as well as moisture conditions for a longer duration of 120 hours. The fabricated ZnO coatings are transparent and highly adhesive. The RF-sputtered ZnO coatings can be proposed as a potential coating on glass packaging used in both healthcare as well as food industries.
Author contributions
JP performed the experiments, data analysis, and conceptualization, and wrote the original draft. SR reviewed, edited, evaluated and documented the results, and supervised the work. All authors have read and agreed to the published version of the manuscript.
Conflicts of interest
We wish to confirm that there are no known conflicts of interest associated with this publication that could have influenced its outcome.
Data availability
The datasets generated during the current study and supporting the findings of this study are included in this paper.
Acknowledgements
The authors are thankful to Robbell Materials Research Centre (OPC) PVT. Ltd, for helping in the antibacterial studies of coated samples. Swift Consultancy, Amritsar, India, is thankfully acknowledged for FESEM measurements.
References
- T. Bintsis, Foodborne pathogens, AIMS Microbiol., 2017, 3(3), 529 Search PubMed.
- B. Devleesschauwer, et al., Methodological framework for World Health Organization estimates of the global burden of foodborne disease, PLoS One, 2015, 10(12), 1–20, DOI:10.1371/journal.pone.0142498.
- W. H. Organization, WHO Global Strategy for Food Safety 2022-2030: towards Stronger Food Safety Systems and Global Cooperation, World Health Organization, 2022 Search PubMed.
- Y. Palanisamy, V. Kadirvel and N. D. Ganesan, Recent technological advances in food packaging: sensors, automation, and application, Sustainable Food Technol., 2025, 3(1), 161–180, 10.1039/D4FB00296B.
- Y. Jiang, Y. Zhang and Y. Deng, Latest Advances in Active Materials for Food Packaging and Their Application, Foods, 2023, 12(22), 4055, DOI:10.3390/foods12224055.
- R. R. Priyanka, R. Yadav, N. Bajal, B. S. Mandal and A. Kumar, Role of active packaging for food freshness and quality maintenance, Int J Environ Agric Biotechnol, 2024, 9(4), 4 Search PubMed.
- J. Zhang, J. Zhang, L. Zhang, Z. Qin and T. Wang, Review of Recent Advances in Intelligent and Antibacterial Packaging for Meat Quality and Safety, Foods, 2025, 14(7), 1157 Search PubMed.
- B. Demirel and M. Erol Taygun, Zinc Oxide-Doped Antibacterial Soda Lime Glass Produced as a Glass Container, ACS Omega, 2023, 8(10), 9257–9264, DOI:10.1021/acsomega.2c07469.
- Q. Zhang, Y. Huo, Q. Yang, F. Zhao, M. Li and J. Ju, Migration of chemical substances from packaging materials to food, Food Chem., 2025, 144544 CrossRef CAS.
- N. Akram, M. Saeed, A. Mansha, and T. H. Bokhari, Metal packaging for food items advantages, disadvantages and, Green Sustainable Process for Chemical and Environmental Engineering and Science: Methods for Producing Smart Packaging, 2023, p. 129 Search PubMed.
- Á. Garrido-López and M. T. Tena, Study of multilayer packaging delamination mechanisms using different surface analysis techniques, Appl. Surf. Sci., 2010, 256(12), 3799–3805, DOI:10.1016/j.apsusc.2010.01.029.
- T. N. Guma and M. M. Maikudi, Corrosion of aluminium metal in food environments and its associated health risk issues: A review, Arid Zone J. Eng. Technol. Environ., 2023, 19(1), 71–84 Search PubMed.
- S. Sharma, S. Jaiswal, B. Duffy and A. K. Jaiswal, Advances in emerging technologies for the decontamination of the food contact surfaces, Food Res. Int., 2022, 151, 110865 CrossRef.
- L. Vrbanc, E. Vrdoljak and F. Derke, Association of Parkinson’s Disease and Exposure to Aluminium and Other Heavy Metals, Rad. Hrvat. akad. znan. umjet. Med. znan., 2024, 565(68–69), 56–63, DOI:10.21857/y26kecg5p9.
- M. Halizahari, M. H. Mohamad, W. Anis and A. Wan, A study on in-flight catering impacts on food waste, Solid State Technol., 2021, 64(2), 4656–4667 Search PubMed.
- Z. Feng, P. Sun, F. Zhao, M. Li and J. Ju, Advancements and challenges in biomimetic materials for food preservation: A review, Food Chem., 2025, 463, 141119 CrossRef CAS PubMed.
- Z. Feng, B. Shao, Q. Yang, Y. Diao and J. Ju, The force of Zein self-assembled nanoparticles and the application of functional materials in food preservation, Food Chem., 2025, 463, 141197 Search PubMed.
- F. Garcia, W.-J. Lin, V. Mellano and G. Davidov-Pardo, Effect of biopolymer coatings made of zein nanoparticles and ε-polylysine as postharvest treatments on the shelf-life of avocados (Persea americana Mill. Cv. Hass), J. Agric. Food Res., 2022, 7, 100260 Search PubMed.
- L. Dong, et al., Effects of Zein-Lecithin-EGCG nanoparticle coatings on postharvest quality and shelf life of loquat (Eriobotrya japonica), LWT–Food Sci. Technol., 2023, 182, 114918 CrossRef CAS.
- J. Wang, Q. Gao, F. Zhao and J. Ju, Repair mechanism and application of self-healing materials for food preservation, Crit. Rev. Food Sci. Nutr., 2024, 64(30), 11113–11123 Search PubMed.
- Z. Feng, et al., Anti-Aspergillus niger mechanism of small molecular combinations of essential oils and their application in extending the shelf-life of bread, Food Biosci., 2025, 64, 105979 Search PubMed.
- M. K. K. Perumal, M. B. S. Rajasekaran, R. R. Renuka, A. V Samrot and M. Nagarajan, Zinc oxide nanoparticles and their nanocomposites as an imperative coating for smart food packaging, Appl. Food Res., 2025, 100849 CrossRef.
- P. J. P. Espitia, N. d. F. F. Soares, J. S. d. R. Coimbra, N. J. de Andrade, R. S. Cruz and E. A. A. Medeiros, Zinc oxide nanoparticles: synthesis, antimicrobial activity and food packaging applications, Food Bioprocess Technol., 2012, 5(5), 1447–1464 CrossRef CAS.
- S. Smaoui, et al., Zinc oxide nanoparticles in meat packaging: A systematic review of recent literature, Food Packag. Shelf Life, 2023, 36, 101045 Search PubMed.
- I. Kim, K. Viswanathan, G. Kasi, S. Thanakkasaranee, K. Sadeghi and J. Seo, ZnO nanostructures in active antibacterial food packaging: Preparation methods, antimicrobial mechanisms, safety issues, future prospects, and challenges, Food Rev. Int., 2022, 38(4), 537–565 CrossRef CAS.
- B. Abebe, E. A. Zereffa, A. Tadesse and H. C. A. Murthy, A review on enhancing the antibacterial activity of ZnO: Mechanisms and microscopic investigation, Nanoscale Res. Lett., 2020, 15(1), 190 Search PubMed.
- N. R. Shanmugam, S. Muthukumar and S. Prasad, A review on ZnO-based electrical biosensors for cardiac biomarker detection, Future Sci. OA, 2017, 3(4), FSO196 CrossRef CAS.
- A. Colniţă, V.-A. Toma, I. A. Brezeştean, M. A. Tahir and N. E. Dina, A review on integrated ZnO-based SERS biosensors and their potential in detecting biomarkers of neurodegenerative diseases, Biosensors, 2023, 13(5), 499 CrossRef.
- J. Gupta, P. A. Hassan and K. C. Barick, Multifunctional ZnO nanostructures: a next generation nanomedicine for cancer therapy, targeted drug delivery, bioimaging, and tissue regeneration, Nanotechnology, 2023, 34(28), 282003, DOI:10.1088/1361-6528/accc35.
- S. Anjum, et al., Recent advances in zinc oxide nanoparticles (ZnO NPs) for cancer diagnosis, target drug delivery, and treatment, Cancers, 2021, 13(18), 4570 CrossRef CAS.
- X. Huang, X. Zheng, Z. Xu and C. Yi, ZnO-based nanocarriers for drug delivery application: From passive to smart strategies, Int. J. Pharm., 2017, 534(1–2), 190–194 CrossRef CAS PubMed.
- S. S. Shaikh, S. M. Kale, N. K. Lotey, M. S. Hate and R. S. Chaughule, Antibacterial activity of biosynthesized nano-zinc oxide from Citrus × aurantiifolia (christm.) Swingle fruit peel against uropathogenic clinical isolates: an in vitro study, Appl. Nanosci., 2025, 15(3), 15, DOI:10.1007/s13204-025-03089-8.
- W. Thongphichai, V. Pongkittiphan, A. Laorpaksa, W. Wiwatcharakornkul and S. Sukrong, Antimicrobial activity against foodborne pathogens and antioxidant activity of plant leaves traditionally used as food packaging, Foods, 2023, 12(12), 2409 CrossRef CAS.
- D. Valerini, et al., Aluminum-doped zinc oxide coatings on polylactic acid films for antimicrobial food packaging, Thin Solid Films, 2018, 645, 187–192, DOI:10.1016/j.tsf.2017.10.038.
- F. Abdel-Wahab, M. Abdel-Baki, S. Ibrahim, M. Abdelnabi and H. Abdelmaksoud, Investigation of oxygen defects in chromium-doped borosilicate glass co-doped with alkali metal (Na2O) and transition metal (ZnO) for photonic applications, Appl. Phys. A, 2025, 131(1), 70 CrossRef CAS.
- M. H. M. Zaid, K. A. Matori, S. H. Abdul Aziz, A. Zakaria and M. S. M. Ghazali, Effect of ZnO on the physical properties and optical band gap of soda lime silicate glass, Int. J. Mol. Sci., 2012, 13(6), 7550–7558, DOI:10.3390/ijms13067550.
- S. Dayioglugil and N. Solak, Effect of ZnO on luminescence performance of terbium-activated zinc borosilicate glasses, Materials, 2024, 17(9), 2154 CrossRef CAS PubMed.
- M. Pérez-González, S. A. Tomás, J. Santoyo-Salazar and M. Morales-Luna, Enhanced photocatalytic activity of TiO2-ZnO thin films deposited by dc reactive magnetron sputtering, Ceram. Int., 2017, 43(12), 8831–8838, DOI:10.1016/j.ceramint.2017.04.016.
- K. Shim, M. Abdellatif, E. Choi and D. Kim, Nanostructured ZnO films on stainless steel are highly safe and effective for antimicrobial applications, Appl. Microbiol. Biotechnol., 2017, 101(7), 2801–2809, DOI:10.1007/s00253-017-8099-6.
- M. K. K. Perumal, M. B. S. Rajasekaran, R. R. Renuka, A. V Samrot and M. Nagarajan, Zinc oxide nanoparticles and their nanocomposites as an imperative coating for smart food packaging, Appl. Food Res., 2025, 100849 Search PubMed.
- V. Puspasari, A. Ridhova, A. Hermawan, M. I. Amal and M. M. Khan, ZnO-based antimicrobial coatings for biomedical applications, Bioprocess Biosyst. Eng., 2022, 45(9), 1421–1445 Search PubMed.
- Ü. Ozgur, D. Hofstetter, and H. Morkoç, ZnO devices and applications: A review of current status and future prospects, in Proceedings of the IEEE, Institute of Electrical and Electronics Engineers Inc., 2010, pp. 1255–1268, DOI:10.1109/JPROC.2010.2044550.
- S. Vyas, A short review on properties and applications of zinc oxide based thin films and devices: ZnO as a promising material for applications in electronics, optoelectronics, biomedical and sensors, Johnson Matthey Technol. Rev., 2020, 64(2), 202–218 Search PubMed.
- D. Valerini, et al., Ag Functionalization of Al-Doped ZnO Nanostructured Coatings on PLA Substrate for Antibacterial Applications, Coatings, 2020, 10(12), 1–13, DOI:10.3390/coatings10121238.
- G. J. Copello, S. Teves, J. Degrossi, M. D'Aquino, M. F. Desimone and L. E. Diaz, Antimicrobial activity on glass materials subject to disinfectant xerogel coating, J. Ind. Microbiol. Biotechnol., 2006, 33(5), 343–348, DOI:10.1007/s10295-005-0066-z.
- L. Kasturi, Chopra – THIN FILM PHENOMENA, McGraw-Hill Book Company, 1969 Search PubMed.
- S. Kumar, J. Pandey, R. Tripathi and S. R. Chauhan, Photoluminescence Investigations and Band Gap Engineering in Environment Friendly ZnO Nanorods: Enhanced Water Treatment Application and Defect Model, ACS Omega, 2023, 8(30), 27732–27742, DOI:10.1021/acsomega.3c03860.
- C. E. Caballero-Güereca, M. R. A. Cruz, E. Luévano-Hipólito and L. M. Torres-Martínez, Transparent ZnO thin films deposited by dip-coating technique: Analyses of their hydrophobic properties, Surf. Interfaces, 2023, 37, 102705 CrossRef.
- N. Fujimura, T. Nishihara, S. Goto, J. Xu and T. Ito, Control of preferred orientation for ZnOx films: control of self-texture, J. Cryst. Growth, 1993, 130(1–2), 269–279 CrossRef CAS.
- D. Bao, H. Gu and A. Kuang, Sol-gel-derived c-axis oriented ZnO thin films, Thin Solid Films, 1998, 312(1–2), 37–39 CrossRef CAS.
- E. Xiang, C. S. Moran, S. Ivanovski and A. Abdal-Hay, Nanosurface texturing for enhancing the antibacterial effect of biodegradable metal zinc: surface modifications, Nanomaterials, 2023, 13(13), 2022 CrossRef CAS.
- P. Bindu and S. Thomas, Estimation of lattice strain in ZnO nanoparticles: X-ray peak profile analysis, J. theor. appl. phys., 2014, 8(4), 123–134, DOI:10.1007/s40094-014-0141-9.
- B. D. Cullity, Elements of X-Ray Diffraction, Hsin Yueh, 1986 Search PubMed.
- S. Rajput and S. Chaudhary, On the superconductivity in in situ synthesized MgB2 tapes, J. Phys. Chem. Solids, 2008, 69(8), 1945–1950, DOI:10.1016/j.jpcs.2008.02.002.
- P. Carvalho, et al., Influence of thickness and coatings morphology in the antimicrobial performance of zinc oxide coatings, Appl. Surf. Sci., 2014, 307, 548–557, DOI:10.1016/j.apsusc.2014.04.072.
- A. Ismail and M. J. Abdullah, The structural and optical properties of ZnO thin films prepared at different RF sputtering power, J. King Saud Univ., Sci., 2013, 25(3), 209–215, DOI:10.1016/J.JKSUS.2012.12.004.
- A. Samavati, H. Nur, A. F. Ismail and Z. Othaman, Radio frequency magnetron sputtered ZnO/SiO2/glass thin film: Role of ZnO thickness on structural and optical properties, J. Alloys Compd., 2016, 671, 170–176, DOI:10.1016/j.jallcom.2016.02.099.
- C. A. Schneider, W. S. Rasband and K. W. Eliceiri, NIH Image to ImageJ: 25 years of image analysis, Nat. Methods, 2012, 9(7), 671–675 CrossRef CAS.
- V. Vibornijs, et al., Analysis of antibacterial and antiviral properties of ZnO and Cu coatings deposited by magnetron sputtering: Evaluation of cell viability and ROS production, Coatings, 2023, 14(1), 14 CrossRef.
- R. Álvarez-Chimal, et al., Influence of the particle size on the antibacterial activity of green synthesized zinc oxide nanoparticles using Dysphania ambrosioides extract, supported by molecular docking analysis, Arabian J. Chem., 2022, 15(6), 103804 CrossRef.
- A. Sirelkhatim, et al., Review on zinc oxide nanoparticles: antibacterial activity and toxicity mechanism, Nano-micro Lett., 2015, 7(3), 219–242 Search PubMed.
- M. Ohring, Materials Science of Thin Films: Depositon and Structure, Academic press, 2002 Search PubMed.
- K. R. Raghupathi, R. T. Koodali and A. C. Manna, Size-dependent bacterial growth inhibition and mechanism of antibacterial activity of zinc oxide nanoparticles, Langmuir, 2011, 27(7), 4020–4028, DOI:10.1021/la104825u.
- N. Babayevska, et al., ZnO size and shape effect on antibacterial activity and cytotoxicity profile, Sci. Rep., 2022, 12(1), 8148 CrossRef CAS.
- B. Demirel and M. E. Taygun, Production of soda lime glass having antibacterial property for industrial applications, Materials, 2020, 13(21), 1–10, DOI:10.3390/ma13214827.
- B. Demirel and M. Erol Taygun, Antibacterial Borosilicate Glass and Glass Ceramic Materials Doped with ZnO for Usage in the Pharmaceutical Industry, ACS Omega, 2023, 8(21), 18735–18742, DOI:10.1021/acsomega.3c00720.
- H. Rokbani, F. Daigle and A. Ajji, Long- and short-term antibacterial properties of low-density polyethylene-based films coated with zinc oxide nanoparticles for potential use in food packaging, J. Plast. Film Sheeting, 2019, 35(2), 117–134, DOI:10.1177/8756087918822677.
- G. Fotie, R. Rampazzo, M. A. Ortenzi, S. Checchia, D. Fessas and L. Piergiovanni, The effect of moisture on cellulose nanocrystals intended as a high gas barrier coating on flexible packaging materials, Polymers, 2017, 9(9), 415 CrossRef PubMed.
|
| This journal is © The Royal Society of Chemistry 2026 |
Click here to see how this site uses Cookies. View our privacy policy here.